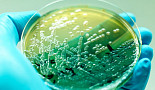
베나톡스, '복합 항생제' 3상

검색
검색어를 입력하세요.
-
사노피, ‘경구 SERD’ 유방암 2상 “PFS 개선 실패”
서윤석 기자 2022-03-16 09:17
-
AZ, ‘린파자’ "초기" 유방암 수술후요법 "FDA 승인"
노신영 기자 2022-03-16 08:13
-
유바이오로직스, '장티푸스 백신' "국내 허가신청"
서윤석 기자 2022-03-15 16:05
-
'유니콘특례 1호' 보로노이, "5년내 FDA 가속승인 4개"
서윤석 기자 2022-03-15 15:01
-
하푼, PSMA 타깃 'CD3 T세포 engager' “개발중단”
신창민 기자 2022-03-15 14:15
-
동화약품-심플렉스, AI기반 면역질환 신약 공동개발
김성민 기자 2022-03-15 14:03
-
BMS, "역대최대 딜" 넥타 'IL-2병용' 흑색종 3상 '실패'
김성민 기자 2022-03-15 12:44
-
애브비, 리히터와 '도파민 조절제' 신약개발 파트너십
노신영 기자 2022-03-15 11:51
-
압타머사이언스, BBB투과 ‘TfR 압타머’ 국제학회 발표
노신영 기자 2022-03-15 11:12
-
美SEC, 中베이진∙자이랩 등 5社 "상폐위험 리스트 올라"
서윤석 기자 2022-03-15 11:06
-
황종연 화연, ‘과거 20년&미래’ TPD 이해 '4가지 관점'
김성민 기자 2022-03-15 09:47
-
HLB 엘레바, 정세호 CEO∙장성훈 COO 영입
서윤석 기자 2022-03-15 09:46
-
베나톡스, '복합 항생제' 3상 "내성감염 치료옵션 기대"
윤소영 기자 2022-03-15 08:53
-
모포시스, M&A 컨스텔레이션 “초기 파이프라인 중단”
신창민 기자 2022-03-15 06:38
-
길리어드, 뉴저지 직원 '114명 해고'.."트로델비 여파?"
노신영 기자 2022-03-14 13:34